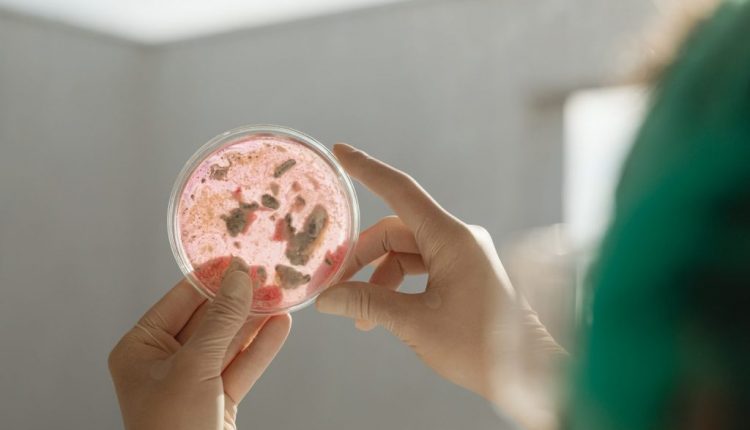

ΠΟΕΔΗΝ: Θετική εξέλιξη για την πορεία της υγείας του 19χρονου φοιτητή με μηνιγγίτιδα
Ο πρόεδρος της ΠΟΕΔΗΝ απευθύνει έκκληση για δωρεάν χορήγηση του εμβολίου κατά της μηνιγγίτιδας Β σε ομάδες υψηλού κινδύνου.
Θετική εξέλιξη παρουσιάζει η κατάσταση της υγείας του 19χρονου φοιτητή που νοσηλεύεται με μικροβιακή μηνιγγίτιδα, καθώς αποσωληνώθηκε και έχει πλέον επικοινωνία με το περιβάλλον.
Ο νεαρός εξακολουθεί να νοσηλεύεται στη ΜΕΘ του νοσοκομείου Τρικάλων, με τους γιατρούς να εκτιμούν ότι δίνει με επιτυχία τη μάχη για τη ζωή του, αν και θα χρειαστεί περαιτέρω νευρολογική αξιολόγηση. Καθοριστική χαρακτηρίζεται η συμβολή του ιατρικού και νοσηλευτικού προσωπικού.
Την ίδια ώρα, το περιστατικό επαναφέρει στο προσκήνιο το ζήτημα της πρόληψης, αναφέρει ο πρόεδρος της ΠΟΕΔΗΝ, Μιχάλης Γιαννάκος.
«Παρά το γεγονός ότι υπάρχει διαθέσιμο εμβόλιο κατά του μηνιγγιτιδόκοκκου τύπου Β, το οποίο προσφέρει υψηλή προστασία, δεν έχει ενταχθεί πλήρως στο Εθνικό Πρόγραμμα Δωρεάν Εμβολιασμών για το σύνολο του πληθυσμού».
Το υψηλό κόστος του εμβολίου, που φτάνει περίπου τα 300 ευρώ συνολικά, (το εμβόλιο κοστίζει περίπου 100 ευρώ η δόση και απαιτούνται δύο με τρεις δόσεις ανάλογα την ηλικία), λειτουργεί αποτρεπτικά, με αποτέλεσμα μεγάλος αριθμός παιδιών και νέων να παραμένει ανεμβολίαστος, σημειώνει ο κ. Γιαννάκος. Πρόκειται για ομάδες υψηλού κινδύνου, όπως μαθητές και φοιτητές, που βρίσκονται συχνά σε συνθήκες συγχρωτισμού.
Αξίζει να σημειωθεί ότι από το 2024 η δωρεάν χορήγηση του εμβολίου αφορά μόνο βρέφη έως 18 μηνών.
Ο κ. Γιαννάκος υπενθυμίζει πρόσφατα περιστατικά, όπως αυτά στην Πάτρα με σοβαρές επιπλοκές και απώλεια ζωής τα οποία έχουν ήδη οδηγήσει πολλούς γονείς να καλύψουν ιδιωτικά το κόστος του εμβολιασμού.
«Η ανάγκη για καθολική πρόσβαση στον εμβολιασμό και για οργανωμένη εκστρατεία ενημέρωσης προβάλλει πλέον ως επιτακτική, με στόχο την αποτροπή νέων σοβαρών περιστατικών και την προστασία της ανθρώπινης ζωής», καταλήγει ο πρόεδρος της ΠΟΕΔΗΝ.
Πηγή: oloygeia.gr

